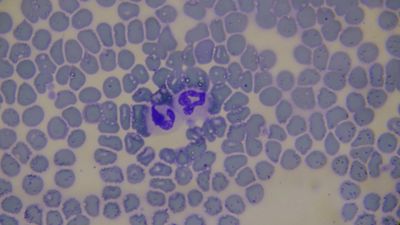

Şu kullanıcı olarak giriş yapıldı:
filler@godaddy.com
Şu kullanıcı olarak giriş yapıldı:
filler@godaddy.com
Sitoloji, en kısa haliyle hücre bilimi şeklinde tanımlanır. Yunanca barındırıcı anlamına gelen kelimeden türetilmiş sitoloji, tıbbın önemli alt dalları arasında yer alır. Sitoloji biliminde uzmanlaşmış kişilere sitolog denir.
Sitoloji bilimi, esas olarak hücreyle ilgilenir. Hücrelerin işleyişi, bölünmesi, yaşam döngüsü gibi hücrenin hayatı boyunca başından geçen her türlü olay, sitolojinin konularına dahildir. İncelenen hücreler, tek hücreli mikroorganizmalara ya da çok hücreli ve gelişmiş insanlara ait olabilir.
Sitolojik inceleme, doku ya da organdan alınan hücrelerin incelenmesi esasına dayanır. Sitoloji laboratuvarlarında uygulanan pek çok yöntem, hastalıklarla ilgili bilgilerin elde edilmesinde tıbbi yardım sağlar. Sitolojik incelemelerin güvenilirliği yüksek ve hata payı düşük olduğundan, çoğu hastalığın tanı ve tedavi sürecinde sitolojiden faydalanılır.
Hücrelerin detaylı incelenmesi için uygulanan sitoloji testleri; hastalığın çeşidine ve alınan dokuya yapılacak işleme göre seçilir.
Vet Zone Acil Veteriner Kliniği
Koz yatağı Mahallesi, Kaya sultan sokak no:16/B Kadıköy
Web sitesi trafiğini analiz etmek ve web sitesi deneyiminizi optimize etmek amacıyla çerezler kullanıyoruz. Çerez kullanımımızı kabul ettiğinizde, verileriniz tüm diğer kullanıcı verileriyle birlikte derlenir.